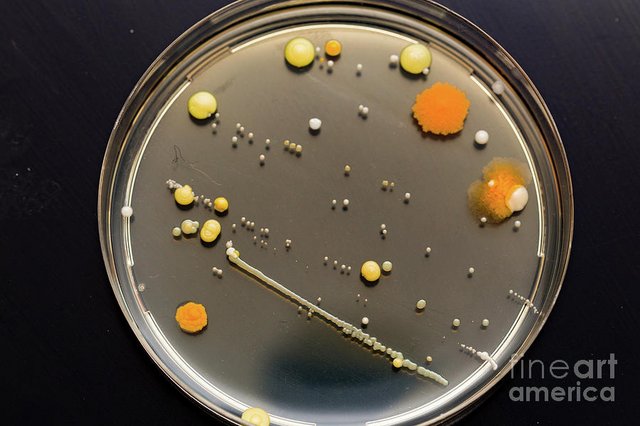

JetBlue Latest and Greatest
#8831
Gets Weekends Off
Joined: Mar 2020
Posts: 537
Likes: 0
Edited since you edited yours
What I said is it would make a lot more sense to transition 900ish 190 guys to the 320 and 220 than put a bunch of people in an untrained (or even trained) 190 status, requiring 2 months of training to a new status once they are needed in the fleets that will stay at jetblue.
If everyone is 320/220 qual�d on lower ALVs and flying a lot less, with credit caps, everyone stays flying, reserves still get used, and people are trained and in the seat/equipment needed to match demand recovery as it happens, which isn�t the case if they are 190 and maybe/maybe not even trained. Then we�d still have the need to transition them and eat the training float when revenue generating pilots are actually needed on the line and not in the sim.
Also, there is a lot of cost savings to be had by eliminating the 190 fleet.
We will likely find out in the next week or so...
What I said is it would make a lot more sense to transition 900ish 190 guys to the 320 and 220 than put a bunch of people in an untrained (or even trained) 190 status, requiring 2 months of training to a new status once they are needed in the fleets that will stay at jetblue.
If everyone is 320/220 qual�d on lower ALVs and flying a lot less, with credit caps, everyone stays flying, reserves still get used, and people are trained and in the seat/equipment needed to match demand recovery as it happens, which isn�t the case if they are 190 and maybe/maybe not even trained. Then we�d still have the need to transition them and eat the training float when revenue generating pilots are actually needed on the line and not in the sim.
Also, there is a lot of cost savings to be had by eliminating the 190 fleet.
We will likely find out in the next week or so...
Last edited by copy; 07-05-2020 at 04:49 PM.
#8832
Line Holder
Joined: Jul 2018
Posts: 725
Likes: 1
Edited since you edited yours
What I said is it would make a lot more sense to transition 900ish 190 guys to the 320 and 220 than put a bunch of people in an untrained (or even trained) 190 status, requiring 2 months of training to a new status once they are needed in the fleets that will stay at jetblue.
If everyone is 320/220 qual�d on lower ALVs and flying a lot less, with credit caps, everyone stays flying, reserves still get used, and people are trained and in the seat/equipment needed to match demand recovery as it happens, which isn�t the case if they are 190 and maybe/maybe not even trained. Then we�d still have the need to transition them and eat the training float when revenue generating pilots are actually needed on the line and not in the sim.
Also, there is a lot of cost savings to be had by eliminating the 190 fleet.
We will likely find out in the next week or so...
What I said is it would make a lot more sense to transition 900ish 190 guys to the 320 and 220 than put a bunch of people in an untrained (or even trained) 190 status, requiring 2 months of training to a new status once they are needed in the fleets that will stay at jetblue.
If everyone is 320/220 qual�d on lower ALVs and flying a lot less, with credit caps, everyone stays flying, reserves still get used, and people are trained and in the seat/equipment needed to match demand recovery as it happens, which isn�t the case if they are 190 and maybe/maybe not even trained. Then we�d still have the need to transition them and eat the training float when revenue generating pilots are actually needed on the line and not in the sim.
Also, there is a lot of cost savings to be had by eliminating the 190 fleet.
We will likely find out in the next week or so...
#8833
Gets Weekends Off
Joined: Feb 2011
Posts: 1,327
Likes: 0
Look these are all great ideas. I personally like the dude who said sone thing about pay or blah blah garbage garbage. (Didn�t really read the whole post) Interesting theory on paper except for the fact that the email says �no changes to CBA pay� or something like that.
AAL merger seems super legit too.
but let�s be honest. They are gunna take our CSPP money. That�s the significance of the May 1 date. Stop your cspp now!
AAL merger seems super legit too.
but let�s be honest. They are gunna take our CSPP money. That�s the significance of the May 1 date. Stop your cspp now!
#8834
Gets Weekends Off
Joined: Mar 2020
Posts: 537
Likes: 0
And I�m all for speculation of ideas and discussing the pros and cons or validity of each, hence why I come on here lol.
And at this point in 2020, I don�t think anything they tell us regarding the LOA, NDA, plan, etc. would be unexpected, no matter what it is. Even if it included murder hornets or Ebola bunnies.
#8835
Line Holder
Joined: Jul 2018
Posts: 725
Likes: 1
Nope, totally allowed to. Just wanted to state my reason for editing my response.
And I�m all for speculation of ideas and discussing the pros and cons or validity of each, hence why I come on here lol.
And at this point in 2020, I don�t think anything they tell us regarding the LOA, NDA, plan, etc. would be unexpected, no matter what it is. Even if it included murder hornets or Ebola bunnies.
And I�m all for speculation of ideas and discussing the pros and cons or validity of each, hence why I come on here lol.
And at this point in 2020, I don�t think anything they tell us regarding the LOA, NDA, plan, etc. would be unexpected, no matter what it is. Even if it included murder hornets or Ebola bunnies.
#8837
Gets Weekends Off
Joined: Dec 2008
Posts: 3,150
Likes: 0
From: Left,Right, Left, Right,Right,Left, Right, Left
#8838
Thread
Thread Starter
Forum
Replies
Last Post